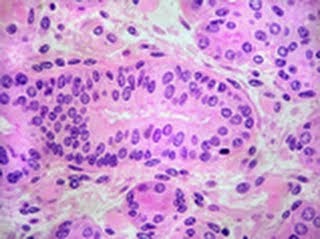

Tejido simple pavimentoso .
Se denomina endotelios. se encuentran en la pared de alvéolos pulmonares y paredes de vasos sanguíneos .
Epitelio simple prismático ciliado.
Se encuentran en el interior de las vías de respiratorias. Ayudan a eliminar sustancias y partículas perjudiciales.
Epitelio simple prismático de borde estriado.
Posee microvellosidades en sus membranas, es el epitelio que reviste el interior del intestino delgado.
Epitelio estratificado pavimentoso queratinizado.
una capa de proteína que es la queratina , también varias capas de células planas.Es el caso de la epidermis.
martes, 13 de enero de 2015
Tejido epitelial
Sus funciones son: protectora y de regulación del intercambio de sustancias entre el interior y el medio externo.
También recubren superficies externas ye internas del organismo realizando un a unión intima entre ellas para no dejar espacios.
Epitelios de revestimiento , recubre superficies y cavidades internas.
-Epitelios simples:
.Pavimentos;Capa de células aplanadas .
.Prismáticos;-Ciliados una capa de células prismáticas con cilios.
-De borde estriado , de una capa de células prismáticas con microvellosidades.
-Epitelios estratificados:
.No queratinizados.
.Queratinizados;Varias capas con una cubierta de queratina
.Prismáticos;3 capas de células prismáticas
-Epitelios glandulares:
.Que segregan sustancias especificas.
También recubren superficies externas ye internas del organismo realizando un a unión intima entre ellas para no dejar espacios.
Epitelios de revestimiento , recubre superficies y cavidades internas.
-Epitelios simples:
.Pavimentos;Capa de células aplanadas .
.Prismáticos;-Ciliados una capa de células prismáticas con cilios.
-De borde estriado , de una capa de células prismáticas con microvellosidades.
-Epitelios estratificados:
.No queratinizados.
.Queratinizados;Varias capas con una cubierta de queratina
.Prismáticos;3 capas de células prismáticas
-Epitelios glandulares:
.Que segregan sustancias especificas.
domingo, 11 de enero de 2015
Organización de un animal
Los animales son seres heterótrofos que ingieren alimentos complejos los cuales deben ser digeridos.
Su estructura corporal consiste en dos tubos concéntricos.
Entre estos dos tubos se disponen tejidos y órganos del animal.
La nutrición heterótrofa es la que determina la estructura interna de los tejidos del animal debido a que este tipo de nutrición determina la necesidad de una percepción de estímulos los cuales se tomad a través de diversos tejidos.
Su estructura corporal consiste en dos tubos concéntricos.
Entre estos dos tubos se disponen tejidos y órganos del animal.
La nutrición heterótrofa es la que determina la estructura interna de los tejidos del animal debido a que este tipo de nutrición determina la necesidad de una percepción de estímulos los cuales se tomad a través de diversos tejidos.
Suscribirse a:
Entradas (Atom)